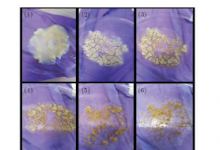

你应该如何使用Android Auto
Android Auto是Google的汽车界面,可在内置信息屏幕上设计智能手机屏幕的简化版本。该系统旨在帮助驾驶员在智能手机上使用流行且至关重要

Android Auto是Google的汽车界面,可在内置信息屏幕上设计智能手机屏幕的简化版本。该系统旨在帮助驾驶员在智能手机上使用流行且至关重要

在超级碗上,公司正在跳槽以兜售电动汽车,但并不是全部。吉普(Jeep)发布了一个超级碗广告,其主要目的是推销最新的《角斗士》,但也简要介

零工经济工作者可能在争取更好条件的努力中赢得了重要的(如果有条件的)战斗。位于芝加哥郊区Skokie的Instacart员工已投票通过其联合食品和

是不喜欢引人入胜的播客介绍,还是不想在每个情节中听到相同的片尾字幕?如果您投资于Apple生态系统,则可能不必忍受。Marco Arment已更新

三星翻盖式可折叠手机可能没有多少神秘之处。经常泄漏的分享者Ben Geskin发布了一段看起来像Galaxy Z Flip原型的视频。就像谣言所暗示的

通用汽车认为,它有一种简单的方法来为其未来的GMCHummer EV进行宣传:给它一种体育迷们会注意到的名人代言。该品牌在超级碗比赛期间(面向

看来,平板电脑市场在2019年相当惨淡。IDC分析师估计,2019年平板电脑的出货量与一年前相比下降了1 5%,其中一些品牌遭受了重大打击。唯一

Xbox自适应控制器已经使得游戏,如果你坐在轮椅上是更方便,但它不会是更好,如果你可以使用轮椅本身作为控制器?你现在可以。AbleGamers慈

来自领先的Android制造商的最新一代智能手机使用USB Type-C连接器,而Apple则在其设备的Lightning端口上押注。因此,该公司严格遵循其战略

博世在2020年国际消费电子展上引起了极大的兴趣,展示了汽车中最古老的概念之一的现代版本。他们有吸引力的产品称为虚拟遮阳板,顾名思义,

骑自行车是解决大城市交通拥堵的好方法。对于许多消费者来说,这是自然界中的首选嗜好。如果您是其中之一,则可能会对学习新的Manta5产品感

在Android设备上复制和粘贴文本是一项有用的功能,可以节省您旅途中的宝贵时间。好消息是,最新版本的操作系统支持内置工具,可让您快速使

由于Pocophone F1的普及,小米已经决定允许POCO作为独立品牌运营。消费者期待这款车型的后继车型首发,我们可能会在2020年底之前看到它。

预计2020年全球智能手机销售将录得几个百分点的增长。缺乏较大增长的原因是许多因素。所有分析师都认为,今年移动行业的领先趋势将是采用5G

Windows 10设备所有者可以通过快速便捷的方式在大屏幕上使用智能手机。您的手机应用程序可以做到这一点,该应用程序会不断更新以提供新功

数据加密是在线消费者安全性的基本要素。该组件是保护智能手机所有者免受黑客和各种监视其活动的技术的关键。传统上,Apple一直享有特别重

在用红外光研究宇宙超过16年之后,揭示了我们太阳系,银河系及其他领域的新奇事物之后,NASA的Spitzer太空望远镜的任务已经结束。任务工程

监督仪器的诺贝尔奖获得者塞缪尔·丁(Samuel Ting)周五说,Alpha电磁光谱仪的工作比以往任何时候都要好。麻省理工学院的物理学家丁说,这
宇宙尘埃是恒星,行星和生命本身化学演化的关键,但其成分尚不十分清楚,我们目前无法收集样品进行分析。有几个例子以陨石的行星际尘埃和彗

前往火星的旅程并非易事,在我们出发之前,有许多问题需要解决。一个有趣的问题是我们如何监视宇航员本身。当然,监视他们的心率和血压很容